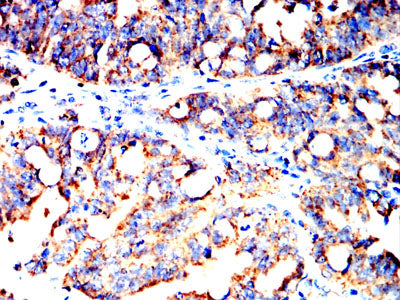

Mouse Monoclonal Antibody to HSPA9
货号:
32301
别名:
CSA; MOT; MOT2; SAAN; CRP40; EVPLS; GRP75; PBP74; GRP-75; HSPA9B; SIDBA4; MTHSP75; HEL-S-124m
应用:
WB,IHC,IF,FCM
反应种属:
Human, Mouse, Monkey, Rat
抗体类型:
Primary antibody
Swissprot:
P38646
规格:
目录价
在线咨询
Description |
|---|
This gene encodes a member of the heat shock protein 70 gene family. The encoded protein is primarily localized to the mitochondria but is also found in the endoplasmic reticulum, plasma membrane and cytoplasmic vesicles. This protein is a heat-shock cognate protein. This protein plays a role in cell proliferation, stress response and maintenance of the mitochondria. A pseudogene of this gene is found on chromosome 2. |
References |
|---|
| 1,Cancer Lett . 2021 Apr 1;502:25-33. 2,Exp Mol Pathol . 2021 Feb;118:104593. |
Specification |
|
|---|---|
| Aliases | CSA; MOT; MOT2; SAAN; CRP40; EVPLS; GRP75; PBP74; GRP-75; HSPA9B; SIDBA4; MTHSP75; HEL-S-124m |
| Entrez GeneID | 3313 |
| Swissprot | P38646 |
| clone | 7E2E4 |
| WB Predicted band size | 74KDa |
| Host/Isotype | Mouse IgG2a |
| Antibody Type | Primary antibody |
| Storage | Store at 4°C short term. Aliquot and store at -20°C long term. Avoid freeze/thaw cycles. |
| Species Reactivity | Human, Mouse, Monkey, Rat |
| Immunogen | Purified recombinant fragment of human HSPA9 (AA: 480-679) expressed in mammalian. |
| Formulation | Purified antibody in PBS with 0.05% sodium azide |
Application |
|
|---|---|
| WB | 1/500 - 1/2000 |
| IHC | 1/200 - 1/1000 |
| IF | 1/200 - 1/1000 |
| FCM | 1/200 - 1/400 |
| ELISA | 1/10000 |
Product Image
-
Black line: Control Antigen (100 ng);Purple line: Antigen (10ng); Blue line: Antigen (50 ng); Red line:Antigen (100 ng)

-
Western blot analysis using HSPA9 mouse mAb against Jurkat (1), HepG2 (2), A431 (3), Hela (4), K562 (5), MCF-7 (6), C2C12 (7), A549 (8), PANC-1 (9), PC-12 (10), C6 (11), COS-7 (12)and NIH3T3 (13) cell lysate.

-
Immunofluorescence analysis of Hela cells using HSPA9 mouse mAb (green). Blue: DRAQ5 fluorescent DNA dye. Red: Actin filaments have been labeled with Alexa Fluor- 555 phalloidin. Secondary antibody from Fisher (Cat#: 35503)

-
Flow cytometric analysis of Jurkat cells using HSPA9 mouse mAb (green) and negative control (red).

-
Flow cytometric analysis of THP-1 cells using HSPA9 mouse mAb (green) and negative control (red).

-
Immunohistochemical analysis of paraffin-embedded human cervical carcinoma tissues using HSPA9 mouse mAb with DAB staining.

-
Immunohistochemical analysis of paraffin-embedded human rectal cancer tissues using HSPA9 mouse mAb with DAB staining.

鄂公网安备42018502007531号
鄂公网安备42018502007531号

